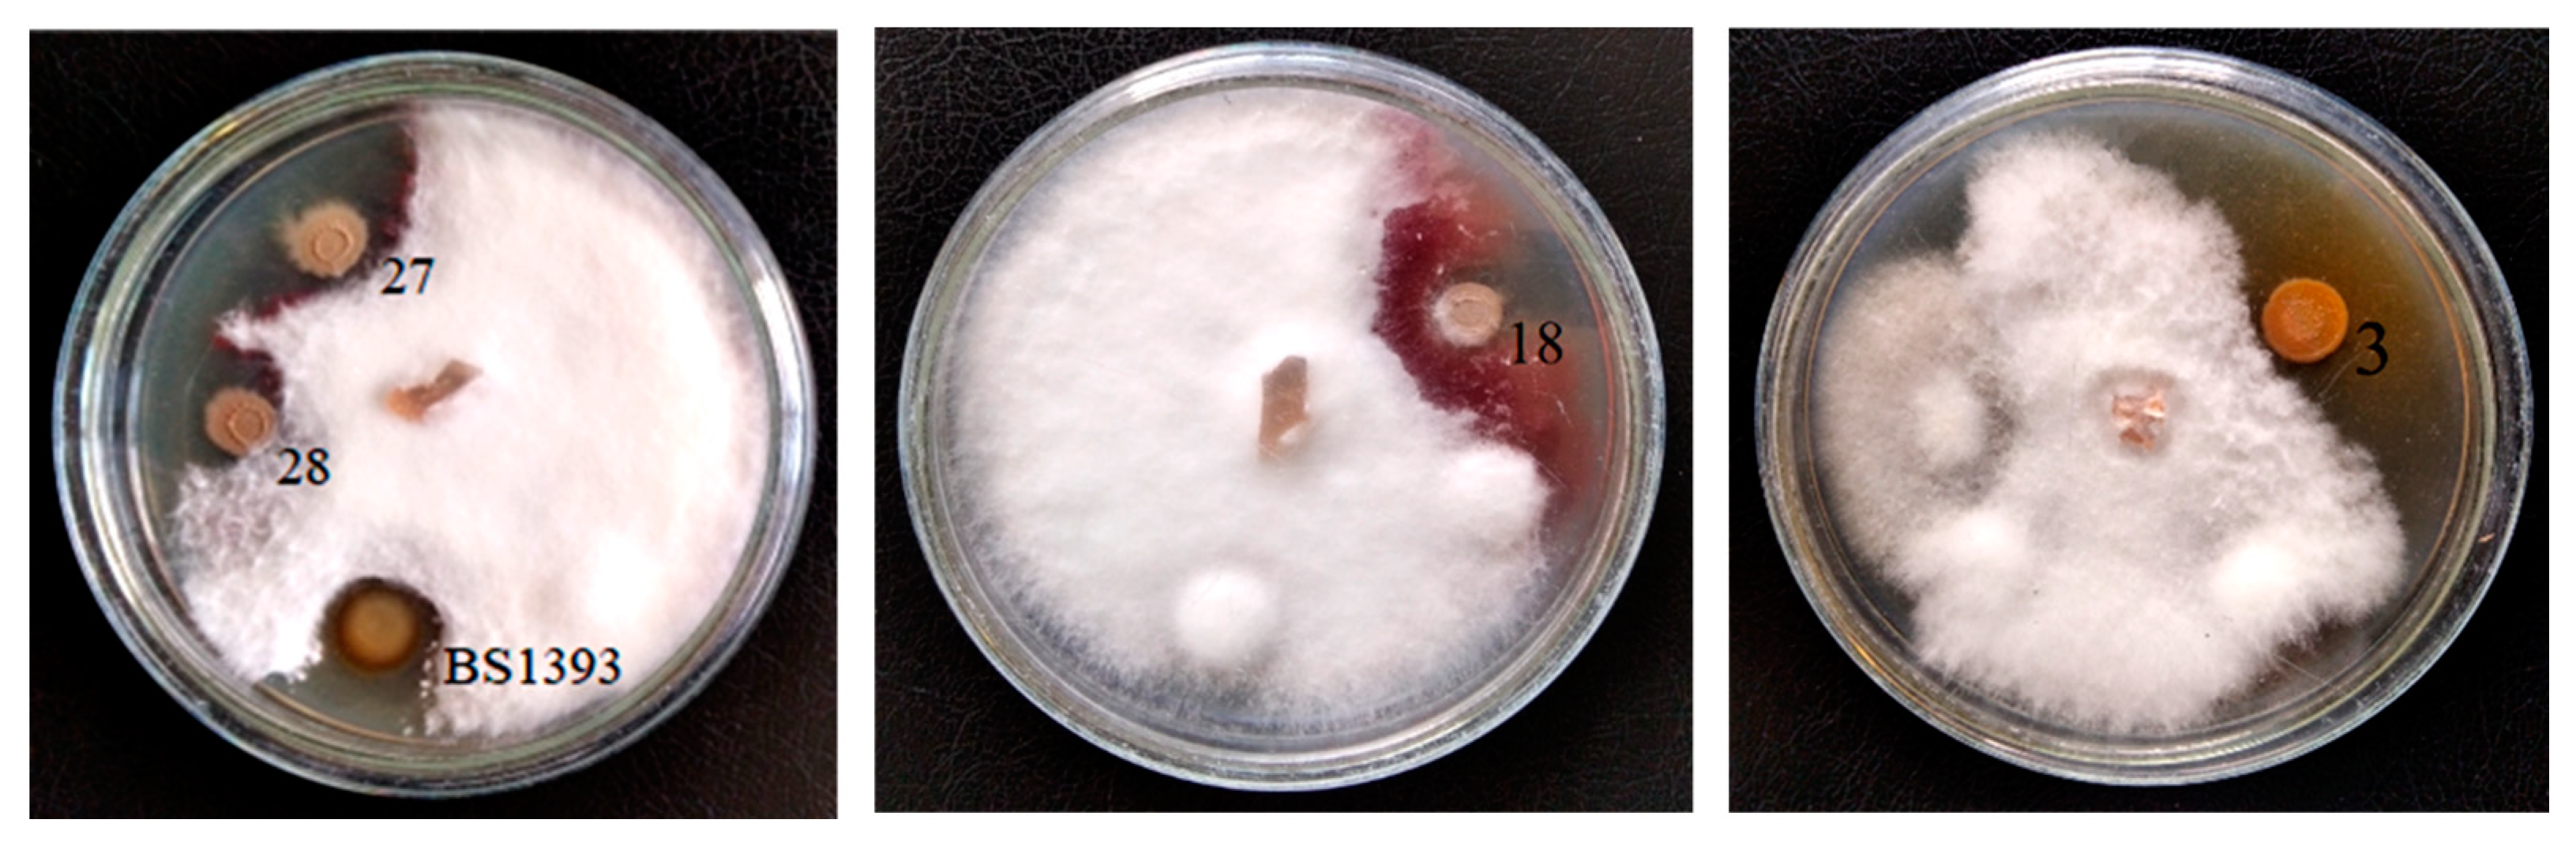
Microorganisms 09 00755 g001 Microorganisms 09 00755 g001
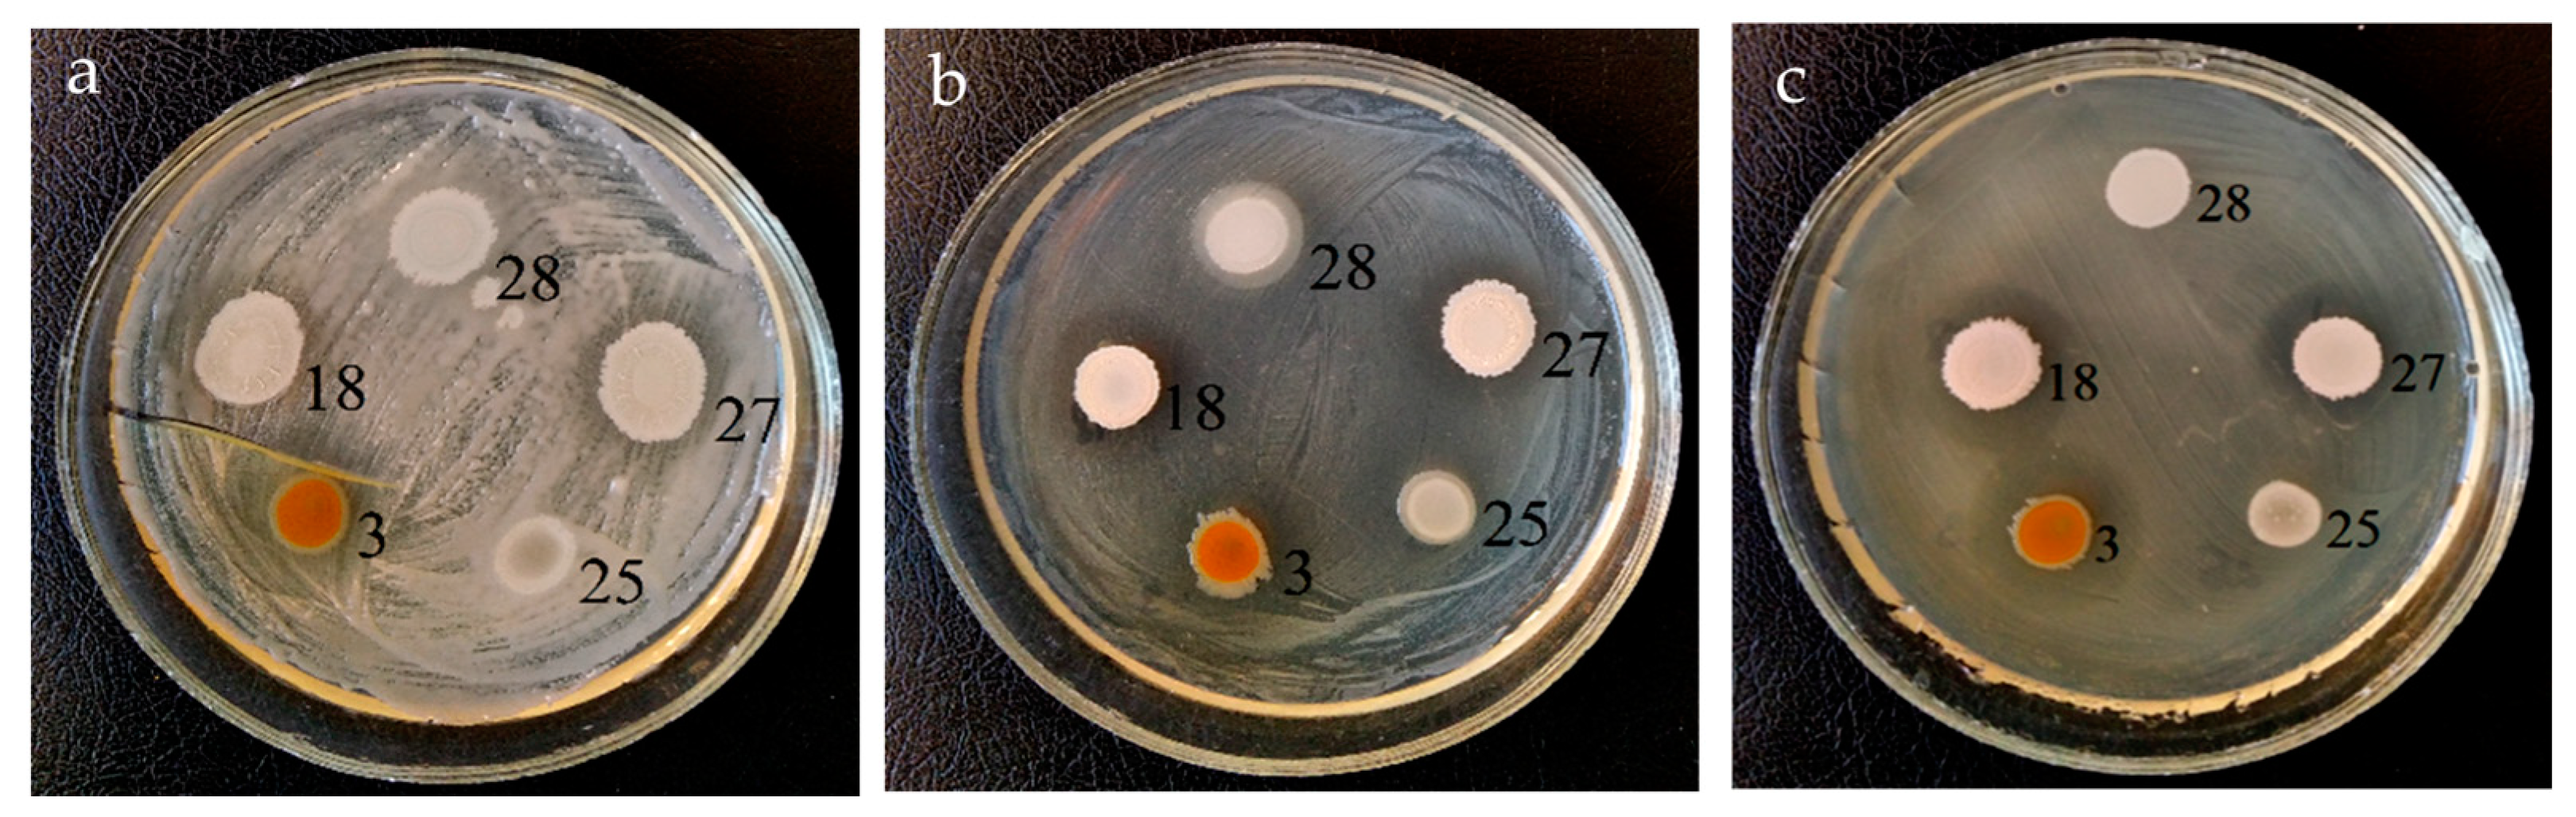
Microorganisms 09 00755 g002 Microorganisms 09 00755 g002

Characterization of Soil Bacteria with Potential to Degrade Benzoate and Antagonistic to Fungal and Bacterial Phytopathogens
Abstract
1. Introduction
2. Material and Methods
2.1. Bacterial Strains and Cultivation Conditions
2.2. Determination of the Antagonistic Activity of Soil Strains
2.3. 16S rRNA Gene Sequencing and Phylogenetic Analysis
2.4. Microscopy
2.5. Characterization of the Biochemical Properties of the Isolated Strains
2.6. Determination of the Degradative Potential of the Isolated Strains
2.7. Statistical Data Processing
3. Results and Discussion
3.1. Antagonistic Activity
3.2. Microscopic Studies
3.3. Strains Identification
3.4. Biochemical Characteristics of Soil Strains
3.5. Degradation Potential of Soil Strains
3.6. Features of the Morphology of Priestia aryabhattai 25
4. Conclusions
Author Contributions
Funding
Acknowledgments
Conflicts of Interest
References
- Daniel, R. The metagenomics of soil. Nat. Rev. Microbiol. 2005, 3, 470–478. [Google Scholar] [CrossRef] [PubMed]
- Condron, L.; Stark, C.; O’Callaghan, M.; Clinton, P.; Huang, Z. The role of microbial communities in the formation and decomposition of soil organic matter. In Soil Microbiology and Sustainable Crop Production; Dixon, G., Tilston, E., Eds.; Springer: Dordrecht, The Netherlands, 2010; pp. 81–117. [Google Scholar]
- Schulz, S.; Brankatschk, R.; Dümig, A.; Kögel-Knabner, I.; Schloter, M.; Zeyer, J. The role of microorganisms at different stages of ecosystem development for soil formation. Biogeosciences 2013, 10, 3983–3996. [Google Scholar] [CrossRef]
- Akhmetov, L.I.; Filonov, A.E.; Puntus, I.F.; Delegan, Y.A.; Deryuscheva, E.I. Mechanisms of naphthalene microbial degradation. In Advances in Chemistry Research, 1st ed.; Taylor, J.C., Ed.; Nova Science Publishers: New York, NY, USA, 2019; Volume 52, pp. 51–121. [Google Scholar]
- Filonov, A.; Akhmetov, L.; Puntus, I.; Solyanikova, I. Removal of oil spills in temperate and cold climates of Russia: Experience in the creation and use of biopreparations based on effective microbial consortia. In Biodegradation, Pollutants and Bioremediation Principles, 1st ed.; Bidoia, E.D., Montagnolli, R.N., Eds.; Taylor & Francis CRC Press: Boca Raton, FL, USA, 2021; pp. 137–159. [Google Scholar]
- Jacobsen, C.S.; Hjelmsø, M.H. Agricultural soils, pesticides and microbial diversity. Curr Opin Biotechnol 2014, 27, 15–20. [Google Scholar] [CrossRef]
- Zegeye, E.K.; Brislawn, C.J.; Farris, Y.; Fansler, S.J.; Hofmockel, K.S.; Jansson, J.K.; Wright, A.T.; Graham, E.B.; Naylor, D.; McClure, R.S.; et al. Selection, succession, and stabilization of soil microbial consortia. mSystems 2019, 4, e00055-19. [Google Scholar] [CrossRef] [PubMed]
- Sutton, N.B.; Maphosa, F.; Morillo, J.A.; Abu Al-Soud, W.; Langenhoff, A.A.M.; Grotenhuis, T.; Rijnaarts, H.H.M.; Smidt, H. Impact of long-term diesel contamination on soil microbial community structure. Appl. Environ. Microbiol. 2013, 79, 619–630. [Google Scholar] [CrossRef] [PubMed]
- Balderas‑Ruíz, K.A.; Bustos, P.; Santamaria, R.I.; González, V.; Cristiano‑Fajardo, S.A.; Barrera‑Ortíz, S.; Mezo‑Villalobos, M.; Aranda‑Ocampo, S.; Guevara‑García, A.A.; Galindo, E.; et al. Bacillus velezensis 83 a bacterial strain from mango phyllosphere, useful for biological control and plant growth promotion. AMB Expr. 2020, 10, 163. [Google Scholar] [CrossRef] [PubMed]
- Gamalero, E.; Favale, N.; Bona, E.; Novello, G.; Cesaro, P.; Massa, N.; Glick, B.R.; del Carmen Orozco-Mosqueda, M.; Berta, G.; Lingua, G. Screening of bacterial endophytes able to promote plant growth and increase salinity tolerance. Appl. Sci. 2020, 10, 5767. [Google Scholar] [CrossRef]
- Souza, R.; Ambrosini, A.; Passaglia, L.M. Plant growth-promoting bacteria as inoculants in agricultural soils. Genet. Mol. Biol. 2015, 38, 401–419. [Google Scholar] [CrossRef]
- Lucy, M.; Reed, E.; Glick, B.R. Applications of free living plant growth-promoting rhizobacteria. Antonie Van Leeuwenhoek 2004, 86, 1–25. [Google Scholar] [CrossRef]
- Gouda, S.; Kerry, R.G.; Das, G.; Paramithiotis, S.; Shin, H.S.; Patra, J.K. Revitalization of plant growth promoting rhizobacteria for sustainable development in agriculture. Microbiol. Res. 2018, 206, 131–140. [Google Scholar] [CrossRef]
- Kozhemyakov, A.P.; Belobrova, S.N.; Orlova, A.G. Creating and analyzing a database on the efficiency of microbial preparations of complex action. Agric. Biol. 2011, 3, 112–115. (In Russian) [Google Scholar]
- Zhukov, V.A.; Shtark, O.Y.; Borisov, A.Y.; Tikhonovich, I.A. Breeding to improve symbiotic effectiveness of legumes. In Plant Breeding from Laboratories to Fields; Andersen, S.B., Ed.; InTech: Rijeka, Croatia, 2013; pp. 167–207. [Google Scholar] [CrossRef]
- Sambrook, J.; Fritsch, E.F.; Maniatis, T. Molecular Cloning: A Laboratory Manual, 2nd ed.; Cold Spring Harbor Laboratory Press: New York, NY, USA, 1989; p. 479. [Google Scholar]
- Ownley, B.H.; Weller, D.M.; Thomashow, L.S. Influence of in situ and in vitro pH on suppression of Gaeumannomyces graminis var. tritici by Pseudomonas fluorescens 2-79. Phytopathology 1992, 82, 178–184. [Google Scholar]
- Koncz, C.; Schell, J. The promoter of TL-DNA gene 5 controls the tissue-specific expression of chimaeric genes carried by a novel type of Agrobacterium binary vector. Mol. Gen. Genet. 1986, 204, 383–396. [Google Scholar] [CrossRef]
- Revenkova, E.V.; Kraev, A.S.; Skryabin, K.G. Construction of disarmed derivative of the supervirulent Ti plasmid pTiBo542. In Plant Biotechnology and Molecular Biology; Skryabin, K.G., Ed.; Pushchino Research Center: Moscow, Russia, 1993; pp. 67–76. [Google Scholar]
- Zakharchenko, N.S.; Pigoleva, S.V.; Kochetkov, V.V.; Chepurnova, M.A.; D’yachenko, O.V.; Lebedeva, A.A.; Zakharchenko, A.V.; Puntus, I.F.; Boronin, A.M.; Bur’yanov, Y.I. Effects of associative pseudomonads and methylobacteria on plant growth and resistance to phytopathogens and xenobiotics. Russ. J. Plant Physiol. 2012, 59, 79–87. [Google Scholar] [CrossRef]
- Siunova, T.V.; Anokhina, T.O.; Sizova, O.I.; Sokolov, S.L.; Sazonova, O.I.; Kochetkov, V.V.; Boronin, A.M.; Patil, S.G.; Chaudhari, A.B. PGPR Pseudomonas strains promising for the development of bioformulations for plant protection and stimulation. Biotechnologia 2017, 33, 56–67. [Google Scholar] [CrossRef]
- Lane, D.J. 16S/23S rRNA sequencing. In Nucleic Acid Techniques in Bacterial Systematic; Stackebrandt, E., Goodfellow, M., Eds.; John Wiley and Sons: New York, NY, USA, 1991; pp. 115–175. [Google Scholar]
- Sanger, F.; Coulson, A.R. A rapid method for determining sequences in DNA by primed synthesis with DNA polymerase. J. Mol. Biol. 1975, 94, 441–448. [Google Scholar] [CrossRef]
- BLAST Program. Available online: http://www.ncbi.nlm.nih.gov/blast (accessed on 1 April 2021).
- EzBioCloud Database. Available online: www.ezbiocloud.net (accessed on 1 April 2021).
- GenBank Database. Available online: www.ncbi.nlm.nih.gov (accessed on 1 April 2021).
- Saitou, N.; Nei, M. The neighbor-joining method: A new method for reconstructing phylogenetic trees. Mol. Biol. Evol. 1987, 4, 406–425. [Google Scholar] [CrossRef]
- Tamura, K.; Peterson, D.; Peterson, N.; Stecher, G.; Nei, M.; Kumar, S. MEGA5: Molecular evolutionary genetics analysis using maximum likelihood, evolutionary distance, and maximum parsimony methods. Mol. Biol. Evol. 2011, 28, 2731–2739. [Google Scholar] [CrossRef] [PubMed]
- Reynolds, E.S. The use of lead citrate at high pH as an electron-opaque stain in electron microscopy. J. Cell. Biol. 1963, 17, 208–213. [Google Scholar] [CrossRef]
- Ermakova, I.T.; Shushkova, T.V.; Leont’evskii, A.A. Microbial degradation of organophosphonates by soil bacteria. Microbiology 2008, 77, 615–620. [Google Scholar] [CrossRef]
- Microsoft Excel 2007 Program. Available online: https://www.microsoft.com/ru-ru/microsoft-365/previous-versions/download-office-2007 (accessed on 1 April 2021).
- Rana, K.L.; Kour, D.; Kaur, T.; Devi, R.; Yadav, A.N.; Yadav, N.; Dhaliwal, H.S.; Saxena, A.K. Endophytic microbes: Biodiversity, plant growth-promoting mechanisms and potential applications for agricultural sustainability. Antonie van Leeuwenhoek 2020, 113, 1075–1107. [Google Scholar] [CrossRef]
- Yadav, A.N.; Kumar, V.; Dhaliwal, H.S.; Prasad, R.; Saxena, A.K. Microbiome in crops: Diversity, distribution, and potential role in crop improvement. In Crop. Improvement through Microbial Biotechnology; Elsevier: Amsterdam, The Netherlands, 2018; pp. 305–332. [Google Scholar] [CrossRef]
- Yu, J.M.; Wang, D.; Pierson, L.S.; Pierson, E.A. Effect of producing different phenazines on bacterial fitness and biological control in Pseudomonas chlororaphis 30-84. Plant. Pathol. J. 2018, 34, 44–58. [Google Scholar] [CrossRef] [PubMed]
- Huang, R.; Feng, Z.; Chi, X.; Sun, X.; Lu, Y.; Zhang, B.; Lu, R.; Luo, W.; Wang, Y.; Miao, J.; et al. Pyrrolnitrin is more essential than phenazines for Pseudomonas chlororaphis G05 in its suppression of Fusarium graminearum. Microbiol. Res. 2018, 215, 55–64. [Google Scholar] [CrossRef]
- Delaney, S.M.; Mavrodi, D.V.; Bonsall, R.F.; Thomashow, L.S. phzO, a gene for biosynthesis of 2-hydroxylated phenazine compounds in Pseudomonas aureofaciens 30-84. J. Bacteriol. 2001, 183, 318–327. [Google Scholar] [CrossRef] [PubMed]
- Schellenberger, U.; Oral, J.; Rosen, B.A.; Wei, J.-Z.; Zhu, G.; Xie, W.; McDonald, M.J.; Cerf, D.C.; Diehn, S.H.; Crane, V.C.; et al. A selective insecticidal protein from Pseudomonas for controlling corn rootworms. Science 2016, 354, 634–637. [Google Scholar] [CrossRef] [PubMed]
- Zaccardelli, M.; Sorrentino, R.; Caputo, M.; Scotti, R.; De Falco, E.; Pane, C. Stepwise-selected Bacillus amyloliquefaciens and B. subtilis strains from composted aromatic plant waste able to control soil-borne diseases. Agriculture 2020, 10, 30. [Google Scholar] [CrossRef]
- Kupper, K.C.; Moretto, R.K.; Fujimoto, A. Production of antifungal compounds by Bacillus spp. isolates and its capacity for controlling citrus black spot under field conditions. World J. Microbiol. Biotechnol. 2020, 36, 7. [Google Scholar] [CrossRef]
- Moreno-Avitia, F.; Utrilla, J.; Bolívar, F.; Nogales, J.; Escalante, A. Metabolic reconstruction of Pseudomonas chlororaphis ATCC 9446 to understand its metabolic potential as a phenazine-1-carboxamide-producing strain. Appl. Microbiol. Biotechnol. 2020, 104, 10119–10132. [Google Scholar] [CrossRef] [PubMed]
- Uz, I.; Duan, Y.P.; Ogram, A. Characterization of the naphthalene degrading bacterium Rhodococcus opacus M213. FEMS Microbiol. Lett. 2000, 185, 231–238. [Google Scholar] [CrossRef]
- Shushkova, T.; Ermakova, I.; Leontievsky, A. Glyphosate bioavailability in soil. Biodegradation 2010, 21, 403–410. [Google Scholar] [CrossRef]
- Donaldson, L.; Nanayakkara, B.; Harrington, J. Wood Growth and Development. Encyclopedia of Applied Plant. Sciences, 2nd ed.; Elsevier Science Publishing Co Inc: San Diego, CA, USA, 2017; pp. 203–210. [Google Scholar]
- Bhattacharyya, C.; Bakshi, U.; Mallick, I.; Mukherji, S.; Bera, B.; Ghosh, A. Genome-guided insights into the plant growth promotion capabilities of the physiologically versatile Bacillus aryabhattai strain AB211. Front. Microbiol. 2017, 8, 411. [Google Scholar] [CrossRef] [PubMed]
- Muniraj, I.; Shameer, S.; Ramachandran, P.; Uthandi, S. Bacillus aryabhattai TFG5-mediated synthesis of humic substances from coir pith wastes. Microb. Cell Fact. 2021, 20, 48. [Google Scholar] [CrossRef] [PubMed]
- Gerke, J. Concepts and misconceptions of humic substances as the stable part of soil organic matter: A review. Agronomy 2018, 8, 76. [Google Scholar] [CrossRef]

| Strain | Identification According 16S rRNA Gene Sequencing | Phytopathogen Suppression Zone, mm | ||
|---|---|---|---|---|
| Fusarium graminearum | Rhizoctonia solani | Gaeumannomyces graminis var. tritici | ||
| 3 | Pseudomonas chlororaphis | 3 ± 1 1 | 2 ± 1 | 2 ± 1 |
| 18 | Bacillus subtilis | ≤1 | – 2 | – |
| 27 | Bacillus subtilis | ≤2 | – | – |
| 28 | Bacillus subtilis | ≤2 | – | – |
| Pseudomonas chlororaphis BS1393 | 2 ± 1 | 3 ± 1 | 2 ± 1 | |
| Test Bacteria | Diameter of the Suppression Zone, mm | ||||
|---|---|---|---|---|---|
| Pseudomonas chlororaphis 3 | Bacillus subtilis 18 | Bacillus subtilis 27 | Bacillus subtilis 28 | Pseudomonas chlororaphis BS1393 (Control) | |
| Pseudomonas savastanoi B-1546 | 16 ± 2 1 | 14 ± 1 | 14 ± 1 | – | 14 ± 1 |
| Pantoea agglomerans ATCC 27155 T | – 2 | – | – | – | – |
| Ralstonia sp. 7-1 | 26 ± 3 | 14 ± 1 | 14 ± 1 | – | 18 ± 3 |
| Pectobacterium carotovorum B-1247 T | 16 ± 2 | 18 ± 2 | 18 ± 2 | – | 16 ± 2 |
| Pectobacterium wasabiae B15 | 15 ± 2 | 18 ± 2 | 18 ± 2 | – | 12 ± 1 |
| Xanthomonas campestris B-610 | 16 ± 1 | – | – | – | 12 ± 1 |
| Xanthomonas campestris B-570 | 16 ± 2 | 14 ± 1 | 14 ± 1 | – | 13 ± 1 |
| Agrobacterium tumefaciens GV3101(pMP90RK) | 18 ± 2 | 12 ± 1 | 16 ± 2 | 16 ± 2 | 18 ± 2 |
| Agrobacterium tumefaciens CBE21 | 26 ± 3 | 12 ± 1 | 12 ± 1 | 12 ± 1 | 18 ± 3 |
| Clavibacter michiganensis Ac-1403 | 16 ± 1 | – | – | – | 13 ± 1 |
| Substrate | Bacillus subtilis 18 | Bacillus subtilis 27 | Bacillus subtilis 28 | Priestia aryabhattai 25 | Pseudomonas chlororaphis 3 |
|---|---|---|---|---|---|
| Glycerol | + | + | + | + | + |
| Erythritol | - | + | - | + | - |
| D-arabinose | - | + | - | + | + |
| L- arabinose | + | + | + | + | + |
| D-ribose | + | + | + | + | + |
| D-xylose | + | + | + | + | + |
| L- xylose | - | - | - | - | - |
| D-adonitol | - | - | - | - | - |
| D-galactose | - | - | - | + | + |
| D-glucose | + | + | + | + | + |
| D-fructose | + | + | + | + | + |
| D-mannose | + | + | + | - | + |
| L-sorbose | - | + | - | - | - |
| L-rhamnose | - | - | - | - | + |
| Dulcitol | - | - | - | - | - |
| Inositol | + | + | + | - | + |
| D-mannitol | + | + | + | + | + |
| D-sorbitol | + | + | + | + | - |
| Methyl -αD- glucopyranoside | + | + | + | - | - |
| N-acetyl- glucosamine | - | - | - | + | - |
| Amygdalin | + | + | + | + | - |
| Arbutin | + | + | + | + | - |
| Esculin | + | + | + | + | + |
| Salicin | + | + | + | + | - |
| D-cellobiose | + | + | + | + | - |
| D-maltose | + | + | + | + | - |
| D-lactose | - | - | - | - | - |
| D-melibiose | + | + | + | + | + |
| D-saccharose | + | + | + | + | + |
| D-trehalose | + | + | + | + | + |
| Inulin | + | + | + | - | - |
| D-melezitose | - | - | - | + | - |
| D-raffinose | + | + | + | + | + |
| amidon (starch) | + | + | + | + | - |
| Glycogen | + | + | + | + | - |
| Xylitol | - | - | - | - | - |
| Gentibiose | + | - | - | + | + |
| D-turanose | + | + | + | + | - |
| D-lyxose | - | - | - | - | - |
| D-tagatose | - | - | - | - | - |
| D-fucose | - | - | - | - | + |
| L- fucose | - | - | - | - | - |
| D-arabitol | - | - | - | - | + |
| L- arabitol | - | - | - | - | - |
| Potassium gluconate | + | + | + | + | + |
| Potassium 2-ketogluconate | + | + | + | + | + |
| Potassium 5-ketogluconate | + | + | + | + | + |
| Reaction | Bacillus subtilis 18 | Bacillus subtilis 27 | Bacillus subtilis 28 | Priestia aryabhattai 25 | Pseudomonas chlororaphis 3 |
|---|---|---|---|---|---|
| β-galactosidase | - | - | - | + | - |
| Arginine dihydrolase | - | + | - | - | + |
| Lysine decarboxylase | - | - | - | - | - |
| Ornithine decarboxylase | - | - | - | - | - |
| Citrate utilization | - | - | - | + | + |
| H2S production | - | - | - | - | - |
| Urease production | - | - | - | - | - |
| Tryptophane deaminase | - | - | - | - | + |
| Indole production | - | - | - | - | - |
| Voges Proskauer | + | + | + | - | - |
| Liquefaction of gelatin | + | + | + | + | + |
| Fermentation of glucose | + | + | + | + | + |
| Fermentation of mannitol | + | + | + | + | + |
| Fermentation of inositol | + | + | + | - | + |
| Fermentation of sorbitol | + | + | + | + | + |
| Fermentation of rhamnose | - | - | - | - | + |
| Fermentation of saccharose | + | + | + | + | + |
| Fermentation of melibiose | - | - | - | - | + |
| Fermentation of amygdalin | + | + | + | + | - |
| Fermentation of arabinose | + | + | + | + | + |
| NO3 reduction to NO2 | - | - | - | - | - |
| NO3 reduction to N2 | - | - | - | - | - |
| Substrates | Bacillus subtilis 18 | Bacillus subtilis 27 | Bacillus subtilis 28 | Priestia aryabhattai 25 | Pseudomonas chlororaphis 3 |
|---|---|---|---|---|---|
| Benzoate | + | + | + | + | + |
| Salicylate | + | + | + | - | - |
| Gentisate | - | - | - | +- | - |
| o-Phthalate | - | +- | +- | - | - |
| Protocatechuate | - | - | - | + | + |
| p-Xylene | - | +- | +- | - | - |
| Toluene | - | - | - | +- | - |
| Hexadecane | - | +- | +- | - | - |
| Diesel fuel | - | +- | +- | +- | - |
| Caprolactam | + | + | + | +- | - |
| Glyphosate | - | - | - | - | + |
Publisher’s Note: MDPI stays neutral with regard to jurisdictional claims in published maps and institutional affiliations. |
© 2021 by the authors. Licensee MDPI, Basel, Switzerland. This article is an open access article distributed under the terms and conditions of the Creative Commons Attribution (CC BY) license (https://creativecommons.org/licenses/by/4.0/).
Share and Cite
Esikova, T.Z.; Anokhina, T.O.; Abashina, T.N.; Suzina, N.E.; Solyanikova, I.P. Characterization of Soil Bacteria with Potential to Degrade Benzoate and Antagonistic to Fungal and Bacterial Phytopathogens. Microorganisms 2021, 9, 755. https://doi.org/10.3390/microorganisms9040755
Esikova TZ, Anokhina TO, Abashina TN, Suzina NE, Solyanikova IP. Characterization of Soil Bacteria with Potential to Degrade Benzoate and Antagonistic to Fungal and Bacterial Phytopathogens. Microorganisms. 2021; 9(4):755. https://doi.org/10.3390/microorganisms9040755
Chicago/Turabian StyleEsikova, Tatiana Z., Tatiana O. Anokhina, Tatiana N. Abashina, Nataliya E. Suzina, and Inna P. Solyanikova. 2021. "Characterization of Soil Bacteria with Potential to Degrade Benzoate and Antagonistic to Fungal and Bacterial Phytopathogens" Microorganisms 9, no. 4: 755. https://doi.org/10.3390/microorganisms9040755
APA StyleEsikova, T. Z., Anokhina, T. O., Abashina, T. N., Suzina, N. E., & Solyanikova, I. P. (2021). Characterization of Soil Bacteria with Potential to Degrade Benzoate and Antagonistic to Fungal and Bacterial Phytopathogens. Microorganisms, 9(4), 755. https://doi.org/10.3390/microorganisms9040755

